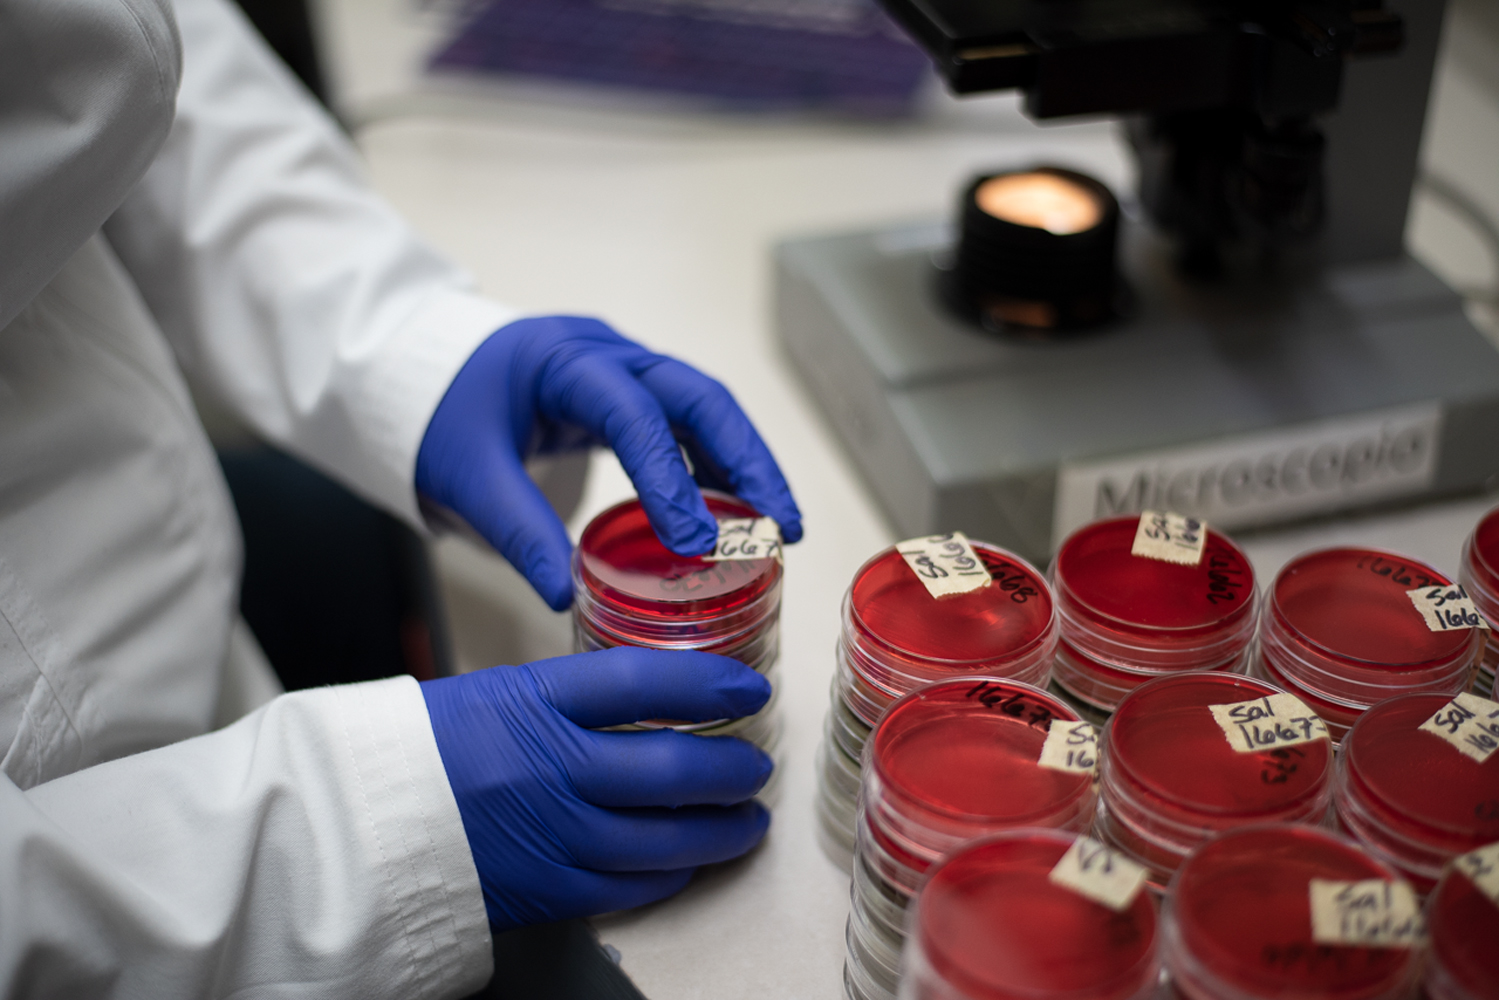

Nuestro laboratorio está equipado con tecnología y métodos actualizados para detección y/o cuantificación de una amplia gama de microorganismos en una amplia variedad de muestras, como:
- Producto terminado
- Materia prima
- Manos
- Superficies
- Agua potable
- Agua residual
- Agua de proceso
- Ambiente
- Hielo
- Canales
- Azúcar
- Farmacéuticos no estériles y afines
- Entre otros…
Tipos de análisis que realizamos:
- Salmonella
- E. coli O157:H7
- E. coli STEC
- Listeria sp y Listeria monocytogenes
- Campylobacter sp
- S. aureus
- Pseudomonas sp y Pseudomonas aeruginosa
- Shigella
- Coliformes totales, coliformes fecales y E. coli
- Clostridium sp , Clostridium perfringens, Clostridium botulinum
- Recuento total
- Mohos y levaduras
- Enterobacterias
- Psicrófilos
- Acidolácticas
- Anaerobios y aerobios previa incubación por 10 días a 35°C
- Identificación automatizada de microorganismos
- Entre otros …
Áreas de aplicaciones
Existen muchos campos en las cuales realizar análisis microbiológicos que pueden ser de utilidad en la industria alimentaria.
Entre ellos se encuentran:
- Control de calidad de producto terminado y materia prima
- Control de inocuidad de producto terminado y materia prima
- Verificación de limpieza microbiológica
- Monitoreo ambiental para cumplimiento con esquemas de inocuidad
- Desarrollo de productos nuevos
- Reformulación de productos
Todo con el objetivo de proteger la salud del consumidor y cumplir con las normativas vigentes.
¿Por qué es importante realizar estos análisis?
Es crucial analizar microbiológicamente para garantizar la seguridad y calidad de alimentos, agua y productos, detectando patógenos que causan enfermedades, así como para identificar microorganismos benéficos en la industria y desarrollar nuevos productos biotecnológicos, protegiendo así la salud del consumidor y mejorando procesos industriales.
Metodologías
Rápidas
Las metodologías rápidas en microbiología son técnicas avanzadas para detectar y cuantificar microorganismos en tiempos más reducidos que los métodos tradicionales, usando técnicas de biología molecular (PCR) y Petrifilms, que aceleran obtener los resultados para liberación de líneas o liberación de lotes en industrias como la alimentaria y farmacéutica, permitiendo decisiones más ágiles y mejorando la seguridad y eficiencia de procesos y productos.
Tradicionales
En las metodologías tradicionales se usan medios de cultivo nutritivos, selectivos y diferenciales además la observación morfológica mediante la tinción de Gram. Junto con las pruebas bioquímicas para identificar enzimas y metabolismo, estos procesos son efectivos pero lentos (días) y requieren de más tiempo que las técnicas moleculares.